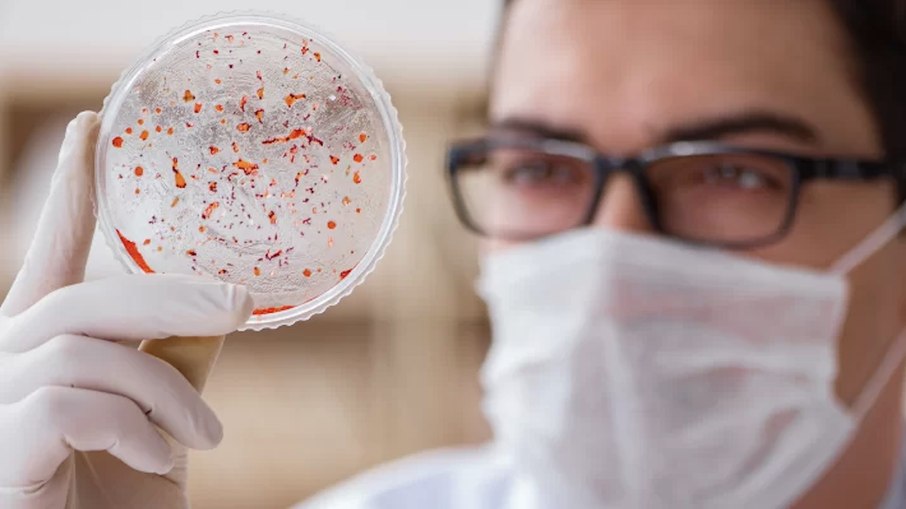
A USP concentrou-se em criar modelos matemáticos para entender a propagação da variante genética

Uma pesquisa com participação de um docente da USP (Universidade de São Paulo) conseguiu alterar geneticamente mosquitos transmissores da malária, ajudando a bloquear o ciclo de transmissão da doença .
O professor Rodrigo Malavazi Corder, do Departamento de Parasitologia do Instituto de Ciências Biomédicas (ICB) da Universidade de São Paulo (USP), foi um dos responsáveis por liderar o estudo que introduziu uma nova variante no Anopheles stephensi, espécie comum na Ásia e em expansão na África.
Como funcionou a modificação genética?
Nos testes de laboratório, os mosquitos geneticamente modificados apresentaram uma taxa de infecção muito menor. Além disso, a alteração não afetou a longevidade, a capacidade reprodutiva ou outras características vitais da espécie.
Para espalhar a variante, os cientistas usaram a técnica chamada gene drive (sistema de impulso genético), que aumenta a chance de um gene ser herdado. “Normalmente, um gene tem 50% de probabilidade de ser transmitido aos descendentes. Com o gene drive, essa taxa pode chegar perto de 100%”, explicou o professor Rodrigo. “Nos experimentos, a frequência de mosquitos com a variante passou de 25% para mais de 90% em apenas dez gerações.”
A equipe do ICB-USP atuou no desenvolvimento de modelos matemáticos que descrevem a dinâmica de propagação da variante genética. “Em cooperação com John Marshall, da Universidade da Califórnia, Berkeley, trabalhamos com dados dos mosquitos transgênicos para entender como a característica genética se dissemina ao longo de diversas gerações”, destacou Corder.
Situação no Brasil
No país, o principal transmissor da malária é o Anopheles darlingi, predominante na Amazônia. Ainda não se sabe se a mesma modificação genética teria efeito nessa espécie. Segundo o pesquisador, já existem conversas preliminares para montar um grupo de pesquisa e avaliar o potencial da técnica com mosquitos e parasitas locais.
A maior parte dos casos de malária no Brasil se concentra na região amazônica, que inclui os estados do Acre, Amapá, Amazonas, Maranhão, Mato Grosso, Pará, Rondônia, Roraima e Tocantins. Nas demais regiões, embora a incidência seja menor, a doença não pode ser negligenciada, pois apresenta maior letalidade.

Transmissão e sintomas
A malária é transmitida pela picada da fêmea do mosquito do gênero Anopheles, infectada por protozoários do gênero Plasmodium. Também pode ocorrer em casos raros por transfusão de sangue, seringas contaminadas, acidentes laboratoriais e transmissão congênita.
Os sintomas incluem febre alta, calafrios, dor de cabeça, cansaço, náuseas e vômitos. Gestantes e crianças estão entre os grupos de maior risco, e a falta de tratamento pode levar à morte.
Prevenção
Não há vacina disponível no Brasil contra a malária. Por isso, a prevenção é baseada em medidas individuais e coletivas: uso de mosquiteiros, roupas compridas, telas em janelas e repelentes, além de ações de saneamento e eliminação de criadouros.
Viajantes que se deslocam para áreas de risco devem ser orientados sobre os sintomas e medidas de proteção, como roupas claras e longas, aplicação de repelente e evitar regiões próximas a rios, lagos e áreas alagadas ao amanhecer e ao entardecer.
Queda nos casos
Segundo o Ministério da Saúde, o Brasil registrou uma redução de 26,8% nos casos de malária entre janeiro e março de 2025 (25.473 registros), em comparação com o mesmo período de 2024 (34.807). O número de óbitos também caiu 27% em 2024, passando de 63 para 43 mortes. Os dados foram apresentados pelo ministro da Saúde, Alexandre Padilha, durante evento pelo Dia Internacional de Luta contra a Malária, celebrado em 25 de abril.